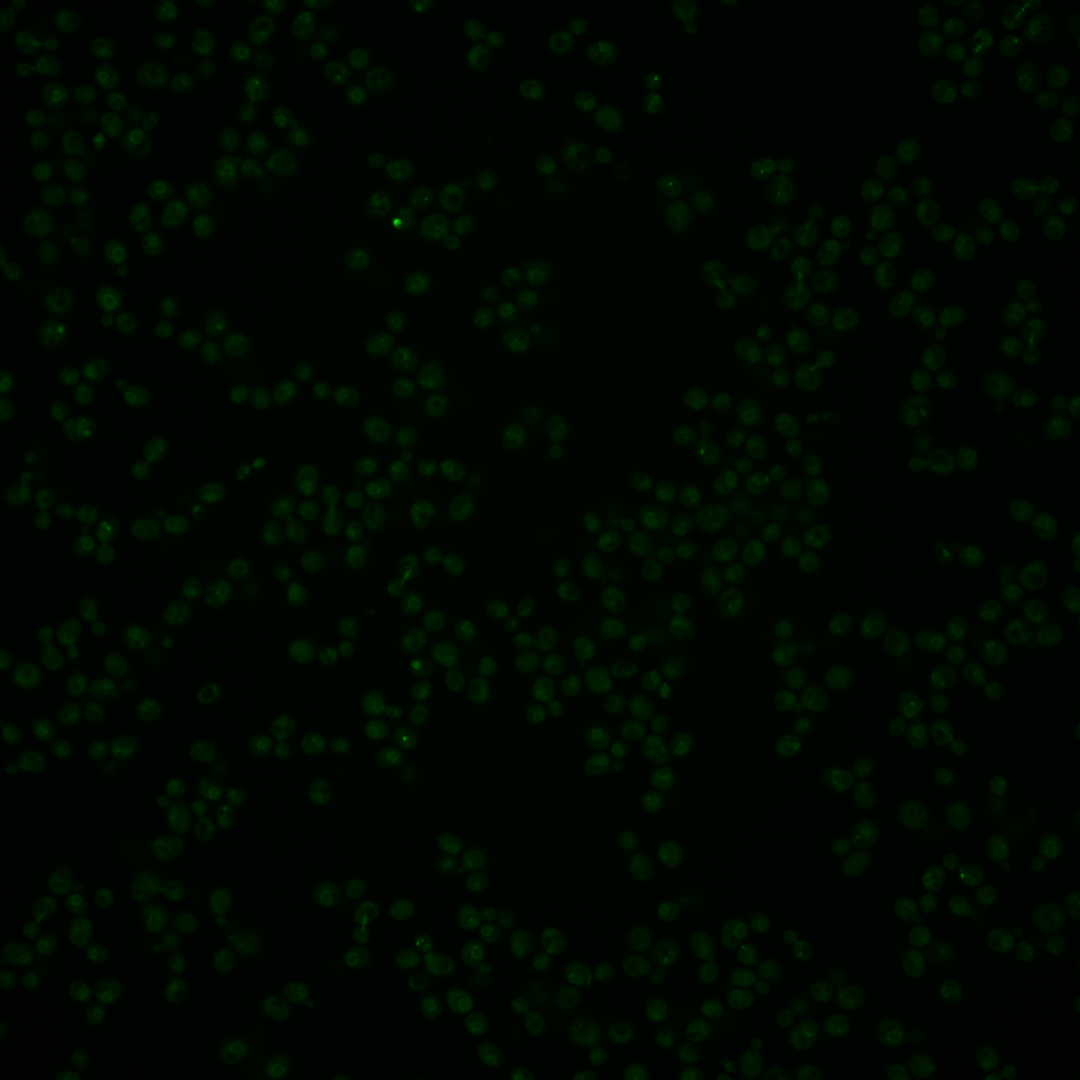
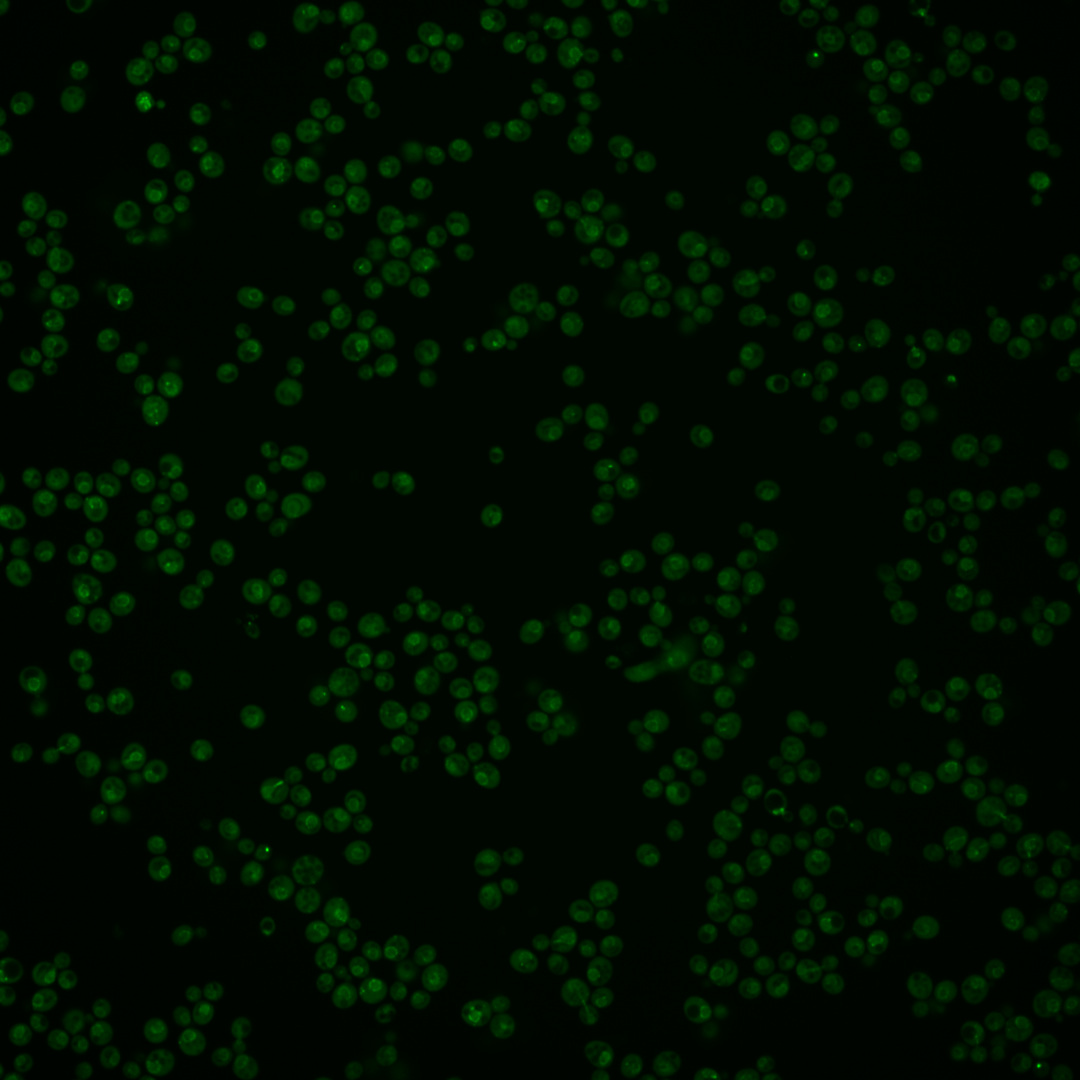
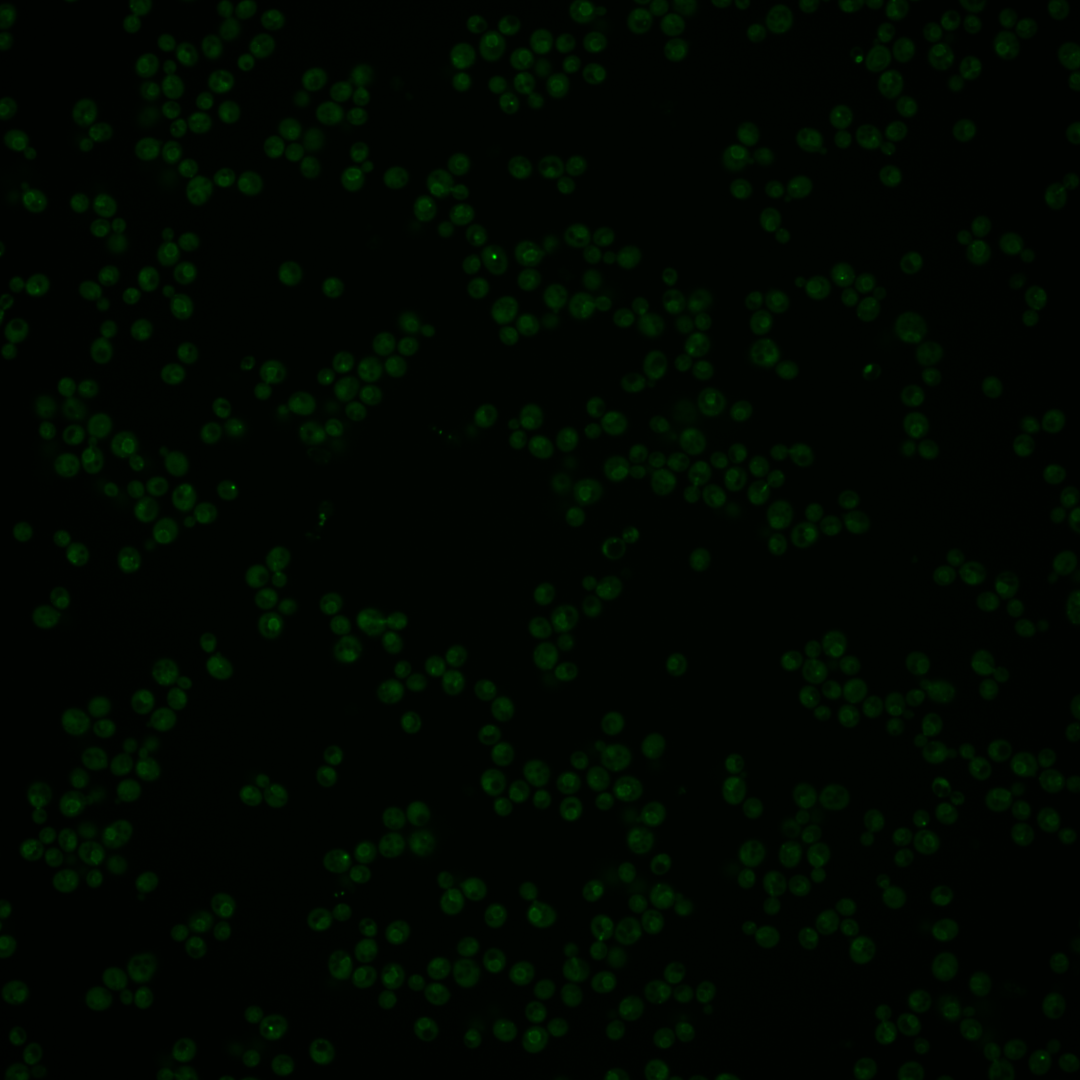
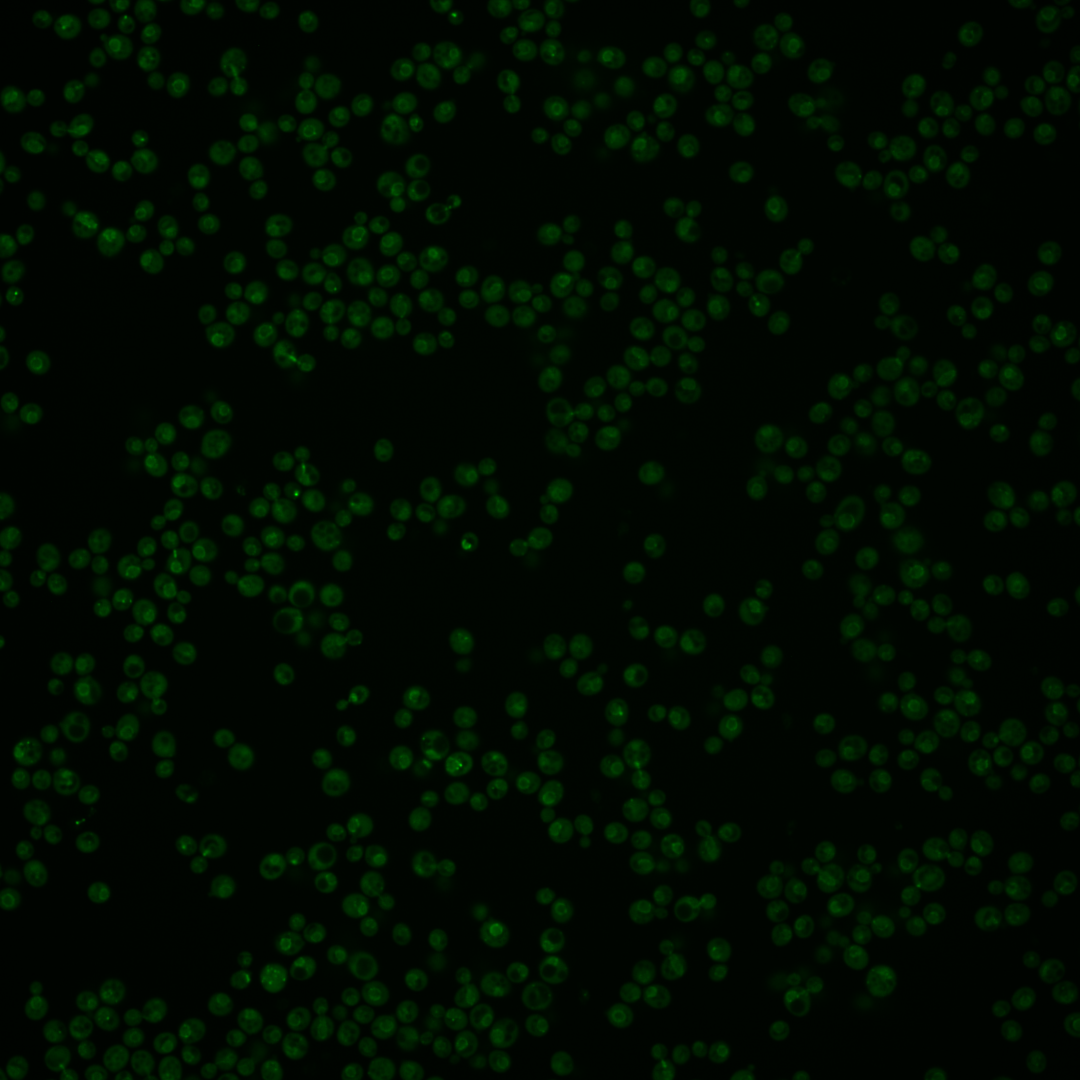

| Standard name | |
|---|---|
| Human Ortholog | |
| Description | Karyopherin alpha homolog; forms a dimer with karyopherin beta Kap95p to mediate import of nuclear proteins, binds the nuclear localization signal of the substrate during import; involved in cotranslational protein degradation; binds ribosome-bound nascent polypeptides; Srp1p and Sts1p couple proteasomes to nascent polypeptides emerging from the ribosome for cotranslational degradation |
Micrographs




















































































Sub-cellular Localization
Yeast GFP Assignment
Protein Abundance
Localization Change
External localization resources
| ensLOC | DeepLoc | |||||||||||||||||||||||
|---|---|---|---|---|---|---|---|---|---|---|---|---|---|---|---|---|---|---|---|---|---|---|---|---|
| Localization | WT1 | WT2 | WT3 | RAP60 | RAP140 | RAP220 | RAP300 | RAP380 | RAP460 | RAP540 | RAP620 | RAP700 | HU80 | HU120 | HU160 | rpd3Δ_1 | rpd3Δ_2 | rpd3Δ_3 | WT1 | WT2 | WT3 | AF100 | AF140 | AF180 |
| Cortical Patches | 0 | 5 | 2 | 1 | 6 | 3 | 5 | 4 | 2 | 5 | 1 | 1 | 3 | 2 | 2 | 0 | 0 | 0 | 1 | 5 | 3 | 2 | 3 | 7 |
| Bud | 0 | 0 | 2 | 2 | 4 | 4 | 13 | 14 | 11 | 10 | 2 | 0 | 1 | 1 | 3 | 0 | 0 | 0 | 0 | 19 | 4 | 18 | 35 | 38 |
| Bud Neck | 0 | 0 | 1 | 1 | 3 | 2 | 5 | 2 | 2 | 2 | 1 | 0 | 1 | 1 | 0 | 2 | 0 | 1 | 0 | 1 | 0 | 2 | 2 | 8 |
| Bud Site | 0 | 0 | 1 | 0 | 0 | 0 | 1 | 3 | 2 | 1 | 0 | 0 | 0 | 0 | 0 | 0 | 0 | 0 | – | – | – | – | – | – |
| Cell Periphery | 0 | 0 | 0 | 0 | 0 | 1 | 2 | 0 | 2 | 7 | 0 | 1 | 0 | 0 | 1 | 1 | 1 | 4 | 0 | 0 | 0 | 3 | 0 | 2 |
| Cytoplasm | 60 | 147 | 123 | 128 | 163 | 199 | 166 | 230 | 184 | 183 | 32 | 75 | 470 | 403 | 551 | 207 | 157 | 133 | 24 | 81 | 85 | 255 | 246 | 234 |
| Endoplasmic Reticulum | 6 | 26 | 8 | 11 | 7 | 7 | 5 | 4 | 12 | 11 | 4 | 7 | 27 | 8 | 5 | 4 | 13 | 7 | 20 | 32 | 7 | 5 | 7 | 9 |
| Endosome | 3 | 3 | 1 | 3 | 14 | 11 | 17 | 9 | 2 | 4 | 1 | 1 | 3 | 10 | 5 | 2 | 3 | 1 | 6 | 35 | 18 | 20 | 18 | 32 |
| Golgi | 7 | 22 | 2 | 8 | 9 | 4 | 4 | 2 | 1 | 1 | 1 | 0 | 5 | 12 | 9 | 1 | 0 | 1 | 0 | 0 | 1 | 1 | 5 | 3 |
| Mitochondria | 0 | 1 | 5 | 7 | 8 | 48 | 63 | 79 | 97 | 81 | 19 | 35 | 0 | 2 | 1 | 7 | 1 | 4 | 0 | 1 | 7 | 14 | 13 | 18 |
| Nucleus | 0 | 0 | 0 | 0 | 0 | 0 | 3 | 9 | 3 | 4 | 0 | 0 | 0 | 1 | 3 | 2 | 3 | 2 | 4 | 24 | 1 | 2 | 2 | 4 |
| Nuclear Periphery | 0 | 0 | 0 | 0 | 1 | 0 | 1 | 2 | 1 | 2 | 0 | 0 | 0 | 1 | 1 | 1 | 0 | 0 | 53 | 113 | 22 | 14 | 12 | 14 |
| Nucleolus | 4 | 15 | 0 | 1 | 10 | 6 | 16 | 17 | 5 | 8 | 1 | 1 | 2 | 7 | 3 | 0 | 0 | 0 | 0 | 7 | 0 | 0 | 1 | 1 |
| Peroxisomes | 0 | 2 | 0 | 0 | 0 | 0 | 0 | 0 | 0 | 0 | 0 | 0 | 0 | 2 | 6 | 0 | 0 | 0 | 0 | 0 | 0 | 0 | 0 | 1 |
| SpindlePole | 1 | 2 | 0 | 1 | 2 | 3 | 4 | 5 | 6 | 4 | 1 | 1 | 3 | 2 | 4 | 1 | 1 | 1 | 4 | 27 | 4 | 12 | 13 | 17 |
| Vac/Vac Membrane | 37 | 155 | 18 | 15 | 25 | 10 | 35 | 57 | 14 | 15 | 5 | 4 | 46 | 42 | 49 | 4 | 12 | 3 | 11 | 90 | 8 | 26 | 29 | 28 |
| Unique Cell Count | 108 | 344 | 155 | 165 | 229 | 253 | 277 | 363 | 284 | 274 | 60 | 103 | 549 | 477 | 626 | 214 | 171 | 141 | 134 | 453 | 172 | 389 | 402 | 437 |
| Labelled Cell Count | 118 | 378 | 163 | 178 | 252 | 298 | 340 | 437 | 344 | 338 | 68 | 126 | 561 | 494 | 643 | 232 | 191 | 157 | 134 | 453 | 172 | 389 | 402 | 437 |
Yeast GFP Assignment
Protein Abundance
| Screen | WT1 | WT2 | WT3 | RAP60 | RAP140 | RAP220 | RAP300 | RAP380 | RAP460 | RAP540 | RAP620 | RAP700 | HU80 | HU120 | HU160 | rpd3Δ_1 | rpd3Δ_2 | rpd3Δ_3 | AF100 | AF140 | AF180 |
|---|---|---|---|---|---|---|---|---|---|---|---|---|---|---|---|---|---|---|---|---|---|
| Mean Cell GFP Intensity (1e-4) | 26.5 | 29.0 | 8.7 | 9.1 | 8.5 | 6.9 | 6.7 | 7.2 | 6.0 | 6.3 | 7.5 | 5.6 | 10.5 | 10.1 | 9.5 | 5.2 | 6.0 | 5.8 | 7.6 | 8.3 | 8.6 |
| Std Deviation (1e-4) | 5.5 | 6.9 | 7.0 | 7.6 | 6.7 | 6.1 | 5.2 | 5.5 | 5.0 | 5.1 | 5.2 | 5.3 | 10.1 | 10.2 | 9.2 | 2.3 | 1.7 | 1.8 | 7.7 | 7.9 | 7.5 |
| Intensity Change (Log2) | – | – | – | 0.06 | -0.04 | -0.33 | -0.37 | -0.27 | -0.55 | -0.45 | -0.21 | -0.64 | 0.27 | 0.21 | 0.12 | -0.73 | -0.53 | -0.59 | -0.19 | -0.07 | -0.01 |
Localization Change
| Localization | RAP60 | RAP140 | RAP220 | RAP300 | RAP380 | RAP460 | RAP540 | RAP620 | RAP700 | HU80 | HU120 | HU160 | rpd3Δ_1 | rpd3Δ_2 | rpd3Δ_3 |
|---|---|---|---|---|---|---|---|---|---|---|---|---|---|---|---|
| Cortical Patches | 0 | 0 | 0 | 0 | 0 | 0 | 0 | 0 | 0 | 0 | 0 | 0 | 0 | 0 | 0 |
| Bud | 0 | 0 | 0 | 1.9 | 0 | 0 | 0 | 0 | 0 | 0 | 0 | 0 | 0 | 0 | 0 |
| Bud Neck | 0 | 0 | 0 | 0 | 0 | 0 | 0 | 0 | 0 | 0 | 0 | 0 | 0 | 0 | 0 |
| Bud Site | 0 | 0 | 0 | 0 | 0 | 0 | 0 | 0 | 0 | 0 | 0 | 0 | 0 | 0 | 0 |
| Cell Periphery | 0 | 0 | 0 | 0 | 0 | 0 | 0 | 0 | 0 | 0 | 0 | 0 | 0 | 0 | 0 |
| Cytoplasm | -0.4 | -1.8 | -0.2 | -4.1 | -3.6 | -3.2 | -2.8 | -3.8 | -1.2 | 1.9 | 1.5 | 2.8 | 5.4 | 3.2 | 3.8 |
| Endoplasmic Reticulum | 0.6 | -1.0 | -1.2 | 0 | 0 | -0.4 | -0.6 | 0 | 0.5 | -0.1 | 0 | 0 | -1.8 | 0.9 | -0.1 |
| Endosome | 0 | 2.7 | 0 | 2.7 | 0 | 0 | 0 | 0 | 0 | 0 | 0 | 0 | 0 | 0 | 0 |
| Golgi | 0 | 0 | 0 | 0 | 0 | 0 | 0 | 0 | 0 | 0 | 0 | 0 | 0 | 0 | 0 |
| Mitochondria | 0.5 | 0.1 | 4.6 | 5.3 | 5.2 | 7.3 | 6.5 | 5.9 | 6.7 | 0 | 0 | 0 | 0 | 0 | 0 |
| Nucleus | 0 | 0 | 0 | 0 | 0 | 0 | 0 | 0 | 0 | 0 | 0 | 0 | 0 | 0 | 0 |
| Nuclear Periphery | 0 | 0 | 0 | 0 | 0 | 0 | 0 | 0 | 0 | 0 | 0 | 0 | 0 | 0 | 0 |
| Nucleolus | 0 | 0 | 0 | 3.0 | 2.7 | 0 | 0 | 0 | 0 | 0 | 0 | 0 | 0 | 0 | 0 |
| Peroxisomes | 0 | 0 | 0 | 0 | 0 | 0 | 0 | 0 | 0 | 0 | 0 | 0 | 0 | 0 | 0 |
| SpindlePole | 0 | 0 | 0 | 0 | 0 | 0 | 0 | 0 | 0 | 0 | 0 | 0 | 0 | 0 | 0 |
| Vacuole | -0.7 | -0.2 | -3.0 | 0.3 | 1.2 | -2.6 | -2.3 | -0.7 | -2.2 | -1.2 | -1.0 | -1.5 | -3.9 | -1.4 | -3.2 |
External localization resources
Images






























Protein Concentration and Protein Localization Data
| R1 | R2 | R3 | ||||||||||||||||
|---|---|---|---|---|---|---|---|---|---|---|---|---|---|---|---|---|---|---|
| G1 Pre-START | G1 Post-START | S/G2 | Metaphase | Anaphase | Telophase | G1 Pre-START | G1 Post-START | S/G2 | Metaphase | Anaphase | Telophase | G1 Pre-START | G1 Post-START | S/G2 | Metaphase | Anaphase | Telophase | |
| Concentration | – | – | – | – | – | – | – | – | – | – | – | – | – | – | – | – | – | – |
| Actin | 0.3317 | 0.0014 | 0.0002 | 0.0001 | 0.003 | 0.0043 | 0.0623 | 0.0026 | 0.0319 | 0.0026 | 0.0006 | 0.004 | 0.0053 | 0.0055 | 0.0113 | 0.001 | 0.1109 | 0.017 |
| Bud | 0.006 | 0.0001 | 0 | 0 | 0.0001 | 0.0004 | 0.0004 | 0.0005 | 0.0003 | 0.0001 | 0 | 0.0001 | 0.0006 | 0.001 | 0.0002 | 0.0001 | 0.0013 | 0.0006 |
| Bud Neck | 0.0023 | 0.0001 | 0.0002 | 0 | 0.001 | 0.002 | 0.0005 | 0.0001 | 0.0005 | 0.0002 | 0.0001 | 0.0041 | 0.0007 | 0.0008 | 0.0007 | 0.0001 | 0.0025 | 0.0046 |
| Bud Periphery | 0.0148 | 0 | 0 | 0 | 0 | 0.0004 | 0.0005 | 0.0002 | 0.0003 | 0.0001 | 0 | 0.0001 | 0.0007 | 0.0005 | 0.0003 | 0 | 0.0011 | 0.0004 |
| Bud Site | 0.0056 | 0.0001 | 0 | 0 | 0.0001 | 0.0005 | 0.0008 | 0.0006 | 0.0028 | 0.0003 | 0 | 0.0001 | 0.0054 | 0.0022 | 0.0026 | 0 | 0.0014 | 0.0001 |
| Cell Periphery | 0.0015 | 0 | 0 | 0 | 0 | 0.0002 | 0.0002 | 0.0001 | 0.0002 | 0 | 0 | 0 | 0.0005 | 0.0002 | 0.0012 | 0 | 0.0003 | 0.0001 |
| Cytoplasm | 0.0037 | 0.4059 | 0.4312 | 0.1518 | 0.3367 | 0.2307 | 0.141 | 0.3983 | 0.2905 | 0.2339 | 0.0381 | 0.1121 | 0.1078 | 0.3985 | 0.2605 | 0.5107 | 0.2143 | 0.1677 |
| Cytoplasmic Foci | 0.0047 | 0.0315 | 0.0003 | 0 | 0.0031 | 0.0185 | 0.0308 | 0.0258 | 0.0092 | 0.0271 | 0.1405 | 0.0305 | 0.0661 | 0.0261 | 0.0385 | 0.0172 | 0.0307 | 0.0072 |
| Eisosomes | 0.0032 | 0 | 0 | 0 | 0 | 0.0001 | 0.0005 | 0 | 0.0001 | 0 | 0 | 0 | 0.0002 | 0 | 0.0002 | 0 | 0.0002 | 0.0001 |
| Endoplasmic Reticulum | 0.0629 | 0.0215 | 0.033 | 0.019 | 0.0117 | 0.0146 | 0.0483 | 0.0227 | 0.0337 | 0.0219 | 0.1565 | 0.0285 | 0.0791 | 0.023 | 0.0548 | 0.011 | 0.0224 | 0.048 |
| Endosome | 0.0837 | 0.0014 | 0.0022 | 0.0014 | 0.0081 | 0.0465 | 0.0324 | 0.0233 | 0.0156 | 0.0532 | 0.0451 | 0.0295 | 0.0925 | 0.0141 | 0.0109 | 0.0183 | 0.0619 | 0.0159 |
| Golgi | 0.0387 | 0.0002 | 0 | 0 | 0.0002 | 0.017 | 0.0255 | 0.0058 | 0.0051 | 0.0022 | 0.0066 | 0.0071 | 0.0125 | 0.0013 | 0.0031 | 0.0012 | 0.0153 | 0.0022 |
| Lipid Particles | 0.0152 | 0.0003 | 0 | 0 | 0.0002 | 0.0115 | 0.0113 | 0.0025 | 0.0218 | 0.0049 | 0.0737 | 0.0075 | 0.0487 | 0.0051 | 0.0047 | 0.0167 | 0.0161 | 0.0061 |
| Mitochondria | 0.0524 | 0.0002 | 0.0001 | 0.0001 | 0.0008 | 0.0493 | 0.0055 | 0.0025 | 0.0012 | 0.0012 | 0.0005 | 0.0016 | 0.0044 | 0.0017 | 0.001 | 0.0003 | 0.0057 | 0.0176 |
| None | 0.0134 | 0.0015 | 0.0002 | 0.0001 | 0.0007 | 0.0009 | 0.0106 | 0.0005 | 0.0005 | 0.0033 | 0.0003 | 0.0006 | 0.0188 | 0.0005 | 0.0041 | 0.0007 | 0.004 | 0.0023 |
| Nuclear Periphery | 0.2897 | 0.4232 | 0.4486 | 0.6104 | 0.4724 | 0.4935 | 0.4866 | 0.4327 | 0.5209 | 0.522 | 0.4926 | 0.6659 | 0.3895 | 0.4122 | 0.5139 | 0.3601 | 0.3868 | 0.5868 |
| Nucleolus | 0.0018 | 0.0001 | 0 | 0 | 0.0003 | 0.0012 | 0.0007 | 0.0002 | 0.0002 | 0.0004 | 0.0002 | 0.0006 | 0.0084 | 0.0003 | 0.0001 | 0.0001 | 0.0005 | 0.0002 |
| Nucleus | 0.0138 | 0.0877 | 0.0766 | 0.2117 | 0.1409 | 0.0756 | 0.0896 | 0.0546 | 0.0508 | 0.0508 | 0.0306 | 0.087 | 0.0987 | 0.088 | 0.0756 | 0.0274 | 0.0985 | 0.1068 |
| Peroxisomes | 0.0025 | 0.0005 | 0 | 0 | 0.0002 | 0.0006 | 0.0024 | 0.0005 | 0.0019 | 0.0003 | 0.0014 | 0.0005 | 0.0017 | 0.0002 | 0.0014 | 0.0001 | 0.0052 | 0.0004 |
| Punctate Nuclear | 0.0062 | 0.0202 | 0.0008 | 0.0004 | 0.0126 | 0.0052 | 0.0406 | 0.0163 | 0.0032 | 0.0674 | 0.0048 | 0.0072 | 0.0314 | 0.0106 | 0.005 | 0.0233 | 0.0103 | 0.0063 |
| Vacuole | 0.0108 | 0.0017 | 0.0019 | 0.0011 | 0.0028 | 0.0109 | 0.0036 | 0.0036 | 0.0033 | 0.003 | 0.0019 | 0.0041 | 0.0133 | 0.0043 | 0.0038 | 0.0044 | 0.0042 | 0.0032 |
| Vacuole Periphery | 0.0355 | 0.0025 | 0.0044 | 0.0038 | 0.005 | 0.0161 | 0.006 | 0.0063 | 0.0061 | 0.0051 | 0.0064 | 0.0089 | 0.0135 | 0.0039 | 0.0063 | 0.0073 | 0.0064 | 0.0063 |
Sequencing Data
| R1 | R2 | |||||||||
|---|---|---|---|---|---|---|---|---|---|---|
| G1 Post-START | S/G2 | Metaphase | Anaphase | Telophase | G1 Post-START | S/G2 | Metaphase | Anaphase | Telophase | |
| Gene Expression | 136.1475 | 132.0012 | 141.5341 | 138.0473 | 133.4887 | 108.9931 | 126.5787 | 122.7247 | 125.5343 | 131.7295 |
| Translational Efficiency | 1.8165 | 1.9132 | 1.5014 | 1.6801 | 1.6188 | 2.1479 | 1.6921 | 1.6784 | 1.4837 | 1.4896 |
Hit Data
| Dataset | Hit |
|---|---|
| Protein Concentration | – |
| Protein Localization | ✘ |
| Gene Expression | ✘ |
| Translational Efficiency | ✘ |
Endocytosis
| Temp | Actin Patch (Sac6-tdTomato) | Cortical Patch (Sla1-GFP) | Late Endosome (Snf7-GFP) | Vacuole (Vph1-GFP) |
|---|---|---|---|---|
| 37℃ | ||||
| RT |
Cell Cycle Omics
CYCLoPs (Srp1-GFP)
| Gene / Allele | Actin Patch (Sac6-tdTomato) | Cortical Patch (Sla1-GFP) | Late Endosome (Snf7-GFP) | Vacuole (Sac6-tdTomato) |
|---|
| Gene | Images |
|---|
| Gene | Images |
|---|
Images are not yet available
Images are not yet available